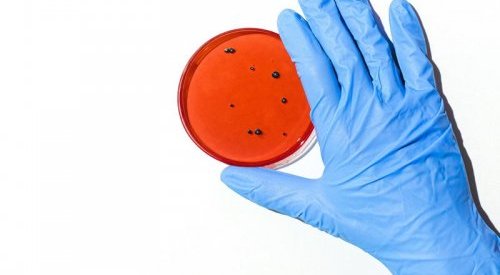

Science, R&D
Une étude pointe les risques de l’octocrylène dans les formules cosmétiques
Filtre organique de protection solaire fréquemment utilisé dans l’élaboration des écrans solaires et crèmes anti-âge, l’octocrylène se...
Silab teste son actif anti-acnéique naturel sur un modèle multifactoriel
Les équipes de recherche avancée de Silab Softcare ont mis au point un modèle 3D d’épiderme reconstruit mimant in vitro la peau acnéique. La...
Amorepacific étudie l’impact de la lumière bleue sur la peau et sa prévention
Le leader coréen des cosmétiques a publié les résultats de travaux de recherche sur l’impact de la lumière bleue sur la peau, ainsi qu’une...
L’UCSD et Silab montrent l’importance de l’homéostasie du microbiote cutané
En 2019, Silab a établi un partenariat de recherche avec le Dr Richard Gallo, spécialiste du microbiote cutané à l’Université de Californie...
L’efficacité du masque en salon de coiffure démontrée par hasard
Contaminés par le coronavirus, deux employés d’un salon de coiffure américain ont porté un masque de protection pendant leurs interactions...
Skinobs lance une plateforme Preclinical Testing
Après avoir lancé il y a quatre ans la première plateforme technologique dédiée aux méthodes et laboratoires de tests cliniques, Skinobs.com...
Kao décrypte les changements morphologiques des lèvres liés à l’âge
Kao a mobilisé ses laboratoires de recherche en maquillage pour décrire et quantifier la façon dont les lèvres se modifie avec l’âge chez...
ScenTree : La classification collaborative des ingrédients de parfums
Une base d’informations fiables sur les ingrédients de parfumerie, structurée pour répondre tant aux questions du parfumeur qu’à celles du...
Des chercheurs de Google apprennent à une IA à reconnaître les odeurs
Dans un article publié la semaine dernière, une équipe de Google Research explique comment elle a utilisé un apprentissage automatique pour...
Kamax Innovative réinvente l’analyse d’actifs cosmétiques
Grâce à sa technologie brevetée XPolar, la startup Kamax Innovative ouvre l’observation optique de la performance des actifs cosmétiques à...